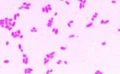

Zestaw 20 preparatów - przyczyny i skutki zanieczyszczenia wody
Cena regularna:
Cena regularna:
towar niedostępny




 5
5
 Opis
Opis
Zestaw dwudziestu gotowych do użytku preparatów mikroskopowych.
Preparaty posiadają 20-letnią gwarancję i dostarczane są w estetycznym, solidnym pudełku.
Zawartość zestawu:
1. Bakterie jelitowe, pałeczka okrężnicy (Escherichia coli) z wód ściekowych
2. Bakteria gnilna (Spirillum) ze szlamu ubogiego w tlen
3. Bakteria gnilna (Sphaerotilus), bakteria formująca długie łańcuchy w otoczce
4. Bakteria szlamowa (Methanobacterium) powodująca powstawanie gazu ściekowego
5. Bakteria siarkowa (Thiocystis)
6. Zakwit wody (Microcystis), sinice „kwitnące” w stojącej wodzie
7. Anabaena, sinica w wodach eutroficznych
8. Skrętnica (Spirogyra), nitkowata zielenica z wód bogatych w składniki odżywcze
9. Spirulina, kształt spiralny, morska sinica
10. Zawłotnia (Chlamydomonas), jednokomórkowa zielenica z wód eutroficznych
11. Gałęzatka (Cladophora), zielenica z gałązkowatymi nićmi z wód średnio zanieczyszczonych
12. Okrzemki, mieszane gatunki z lekko zanieczyszczonych wód
13. Euglena, powszechny zielony wiciowiec występujący w stojących wodach eutroficznych
14. Orzęski (Ciliates), różne gatunki z wód bogatych w składniki odżywcze
15. Wrotki (Rotifera), małe zwierzęta z zanieczyszczonych wód
16. Rureczniki (Tubifex), skąposzczet słodkowodny żyjący w szlamie
17. Carchesium, dzwonkokształtny orzęsek, posiadający stylik z wód średnio zanieczyszczonych
18. Saprolegnia, powodująca chorobę „pleśniawkę”, szkodliwa dla roślin i zwierząt
19. Skóra ryby okaleczonej przez chemikalia, p.p.
20. Wrzód skóry płaza, p.p.